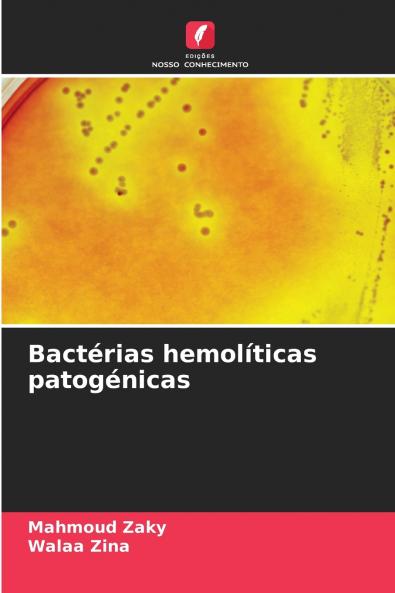
Bactérias hemolíticas patogénicas

Portuguese
Paperback
₹4730
₹6226
24.03% OFF
(All inclusive*)
Delivery Options
Please enter pincode to check delivery time.
*COD & Shipping Charges may apply on certain items.
Review final details at checkout.
Looking to place a bulk order? SUBMIT DETAILS
Delivery Options
Please enter pincode to check delivery time.
*COD & Shipping Charges may apply on certain items.
Review final details at checkout.
About The Book
Description
Author(s)
A capacidade das colónias bacterianas de induzir hemólise quando cultivadas em ágar sangue é utilizada para classificar certos microrganismos. Existem três tipos de hemólise: alfa beta e gama. A hemólise alfa é uma hemólise parcial e é chamada de hemólise verde devido à mudança de cor no ágar. A hemólise beta é uma hemólise completa é uma lise completa dos glóbulos vermelhos no meio e aparece clara e transparente. A hemólise gama é não hemolítica. Uma substância que causa hemólise é a hemolisina. As hemolisinas são certas proteínas e lípidos que causam a lise dos glóbulos vermelhos danificando a sua membrana celular. Embora as hemolisinas sejam capazes de lisar os glóbulos vermelhos in vitro a capacidade das hemolisinas de atingir outras células incluindo os glóbulos brancos é frequentemente responsável pelos efeitos das hemolisinas durante a infecção. As bactérias hemolíticas patogénicas podem ser bactérias gram-positivas tais como (estafilococos estreptococos bacilos e listeria) e bactérias gram-negativas tais como (Neisseria Pseudomonas Haemophilus Helicobacter Escherichi Klebsiella Salmonella Shigella e Proteus). Estude as características gerais de cada bactéria que causa doenças humanas.
Details
ISBN 13
9786202362382
Publication Date
-05-08-2025
Pages
-68
Weight
-106 grams
Dimensions
-152x229x4.14 mm